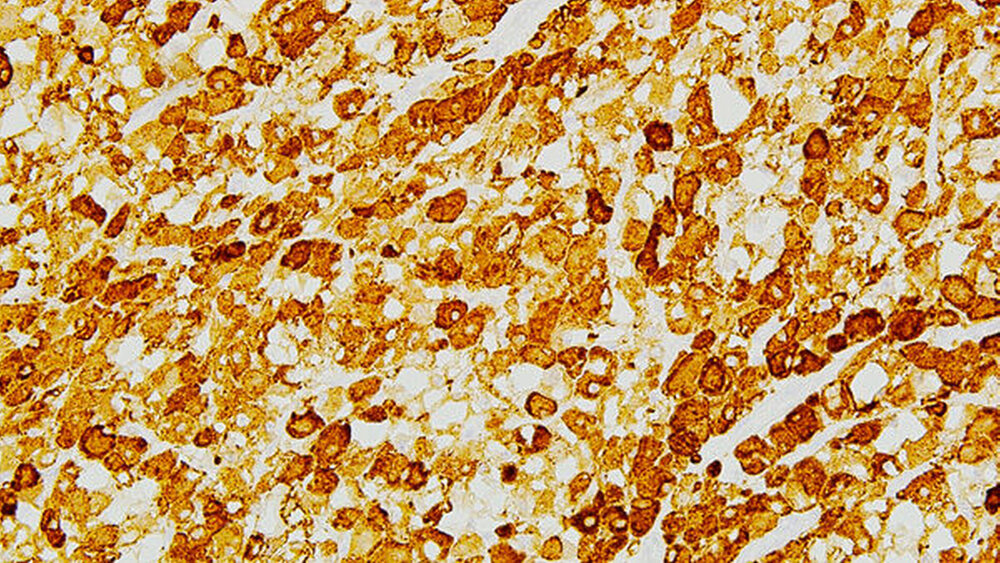
Abbildung 4: Histologisches Präparat (Immunhistochemische Färbung für Desmin, Vergrößerung x200): Die Zellen zeigen eine kräftige zytoplasmatische Färbung für Desmin, ein Intermediärfilament, das sowohl in der Skelett- als auch in der glatten Muskulatur vorkommt. |

Adultes multilokuläres Rhabdomyom im weichen Gaumen
Ein 64-jähriger Patient wurde in der Klinik und Poliklinik für Mund-, Kiefer- und Gesichtschirurgie der Universitätsmedizin Rostock durch die niedergelassenen MKG-chirurgischen Kollegen zur Übernahme der weiteren Therapie einer unklaren Raumforderung im Gaumen rechts vorgestellt. Korrespondierend dazu zeigte sich intraoral eine circa 4 cm große, nur dezent sichtbare Vorwölbung im Bereich des Übergangs vom harten zum weichen Gaumen, die laut Aussage des Patienten zu einer progredienten Beeinträchtigung der oralen Nahrungsaufnahme geführt hatte. Eigenanamnestisch bestand zusätzlich seit mehr als zwölf Monaten ein Globusgefühl mit Räusperzwang.
Bei Verdacht auf ein Schilddrüsenadenom als Causa der beschriebenen Beschwerden war bereits alio loco eine Thyreoidektomie durchgeführt worden. Zu diesem Zeitpunkt ergab die histologische Untersuchung eine Struma colloides nodosa mit multiplen Rhabdomyomen ohne Anhalt auf Malignität. Bei sich nicht einstellender Besserung der Beschwerden des Patienten fiel dem betreuenden Hauszahnarzt eine progredient wachsende, vor allem palpable Raumforderung des weichen Gaumens auf, so dass er den Patienten zur Abklärung HNO-ärztlich und MKG-chirurgisch vorstellte.
Die endoskopische Untersuchung wie auch die MRT-Untersuchung (Abbildung 1) bestätigten den Verdacht auf eine benigne, im Bereich des weichen Gaumens rechts lokalisierte Neoplasie.
Nach Vervollständigung des Stagings ohne Hinweis auf invasives Wachstum sowie auf mögliche Filiae erfolgte bei Verdacht auf eine benigne Raumforderung die Exzision der von einer derben Kapsel umgebenen und nur wenig am umgebenden Gewebe adhärenten Raumforderung in toto (Abbildung 2). Die Wunde wurde nach operativer Blutstillung primär mit auflösbaren Fäden verschlossen.
In der histopathologischen Untersuchung zeigte sich eine Zellproliferation von großkernigen Zellen (Abbildung 3). Die immunhistochemische Untersuchung ergab eine kräftig positive Färbung für Desmin (Abbildung 4). Einige Zellkerne waren mit Myogenin angefärbt. Die Zellen waren schwach positiv für S100 und negativ für Zytokeratin (AE1/3), den Makrophagenmarker CD68 und Melan A. Es fanden sich keine Zellatypien, Mitosen oder Nekrosen. Somit konnte die Diagnose eines adulten Rhabdomyoms der Skelettmuskulatur im Bereich des Weichgaumens gefällt werden.
Der weitere postoperative Verlauf gestaltete sich komplikationslos bei vollständiger Rückbildung der Beschwerdesymptomatik und zeitgerechter Wundheilung. Während einer Nach-Beobachtungszeit von nunmehr sieben Monaten konnte kein Anhalt auf ein Rezidiv gefunden werden.
Diskussion
Echte Rhabdomyome sind äußerst seltene, benigne Tumore unklarer Ätiologie, die sehr langsam wachsen und dem Herz- beziehungsweise Skelettmuskelgewebe entstammen. Sie werden in kardiale und extrakardiale Rhabdomyome unterschieden. Kardiale Rhabdomyome kommen deutlich häufiger als die extrakardiale Form vor und treten in 50 bis 80 Prozent der Fälle im Rahmen der tuberösen Sklerose – einer autosomal-dominant vererbten Erkrankung, die mit Fehlbildungen im Gehirn, Hautveränderungen sowie (zumeist gutartigen) Tumoren in anderen Organsystemen vergesellschaftet ist – auf [Gunther et al., 2008]. Seltener entstehen kardiale Rhabdomyome spontan (20 Prozent). Sie stellen im Kindesalter mit etwa 40 bis 60 Prozent die häufigsten primären Herztumoren dar [Gunther et al., 2008] und sind im Erwachsenenalter eine Seltenheit. Durch den Befall des Herzmuskels kommt es bei kardialen Rhabdomyomen zur diffusen Verformung des Herzmuskels. Sie werden allgemein auch als Hamartome (tumorartige, gutartige Gewebeveränderungen aufgrund von fehlerhaft differenziertem beziehungsweise versprengtem Keimgewebe) angesehen und bilden sich in rund 50 Prozent der Fälle spontan wieder zurück [Jain et al., 2010]. Extrakardiale Rhabdomyome werden weiter in fetale, adulte und vaginale Rhabdomyome unterteilt [Weiss et al., 2008]. Extrakardiale adulte Rhabdomyome, wie im beschriebenen Fall, treten deutlich häufiger bei Männer als bei Frauen (Verhältnis 4:1) auf [Willis et al., 1994].
Das Alter bei Diagnosestellung reicht von zwei bis 80 Jahren und liegt im Durchschnitt bei ungefähr 50 Jahren. Die Hauptprädilektionsstelle ist der Kopf- und Halsbereich (bevorzugt: sublingual, submandibulär, Pharynx, Larynx, Gaumen und Nackenhalsweichteile). Typischerweise zeigen sich adulte Rhabdomyome als solitäre Raumforderungen, die auch multinodulär in der gleichen anatomischen Region auftreten können [Blaauwgeers et al., 1989; Walker et al., 1990]. Ein multifokales Vorkommen wie im beschriebenen Patientenfall und lokale Rezidive nach inkompletter Entfernung [Liess et al., 2005; Kapadia et al., 1993; Willis et al., 1994] sind bekannt und bedürfen einer längerfristigen Nachsorge [Bertholf et al., 1988; Walker et al., 1990].
Das beschriebene adulte multilokuläre (hier: Schilddrüse und Gaumen) extrakardiale Rhabdomyom ist eine Rarität [Liess et al., 2005]. Auch wenn die Erstbeschreibung bereits 1854 erfolgte [Weber, 1854; Zenker, 1864; Weber, 1867], sind bis heute nur 26 Fälle multilokulärer Rhabdomyome weltweit beschrieben worden [de Trey et al., 2013], über einen Befall des Weichgaumens wurde in diesem Zusammenhang noch nie berichtet.
Klinisch berichten Patienten mit Rhabdomyomen im Kopf-Hals-Bereich oftmals über ein cervicales Engegefühl mit Heiserkeit sowie über eine Einschränkung beim Atmen/Schlucken oder auch über eine Hörverschlechterung.
Die präoperative, nicht invasive Diagnostik ist schwierig und nur mittels Magnetresonanztomogramm sinnvoll möglich. Hier zeigen die Tumore eine geringe Hyperintensität und Isointensität in der T1- und in der T2-Wichtung bei insgesamt homogener Signalintensität der glatt begrenzten Raumforderung ohne Infiltration des umgebenden Gewebes. Als Methode zur Diagnosesicherung vor Therapie kommt die Feinnadel- oder die Skalpellbiopsie infrage [Bertholf et al., 1988; McGregor et al., 2003].
Fazit für die Praxis
• Bei anamnestischen Problemen im Kopf-Hals-Bereich ist eine sorgfältige orale Untersuchung nicht erst beim Ausschluss aller anderen Ursachen, sondern bereits im Rahmen der Primärdiagnostik empfehlenswert.
• Bei progredienten Einschränkungen vitaler Funktionen wie der Nahrungsaufnahme sollten neben malignen auch benigne Tumore Berücksichtigung finden.
• Erst eine histologische Untersuchung zeigt die genaue Tumorentität während präoperative Staging-Untersuchungen zumeist lediglich Hinweise auf die Dignität geben können.
Im vorliegenden Fall quoll der Tumor nach der initialen Inzision bereits aus der Wunde und wurde daher ohne vorherige bioptische Sicherung komplett entfernt. Dies stellt auch die definitive Therapie der Wahl dar. Eine maligne Transformation oder eine spontane Rückbildung der adulten extrakardialen Rhabdomyome ist nicht belegt. Differenzialdiagnostisch müssen allerdings auch andere Entitäten wie das Neurofibrom, aber auch maligne Tumore wie Plattenepithelkarzinome, Fibro- und Angiosarkome sowie Lymphome einbezogen werden. Ein Rhabdomyosarkom würde sich radiologisch eher unscharf begrenzt mit diffus infiltrierendem Wachstum und inhomogener Kontrastmittelanreicherung darstellen.
PD Dr. Dr. Peer Wolfgang Kämmerer, MA., Dr. Dr. Michael Dau
Klinik und Poliklinik für Mund-, Kiefer- und Plastische Gesichtschirurgie, Universitätsklinikum Rostock
Schillingallee 35, 18055 Rostock
PD Dr. Stine-Kathrein Kraeft, FCAP
Institut für Pathologie, Universitätsklinikum Rostock
Strempelstr. 14, 18055 Rostock